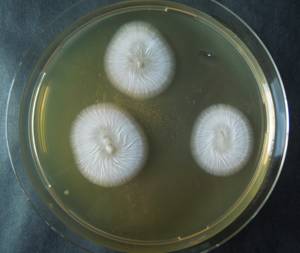
MSU_FS-02709 01, Район Кон Плонг (Kon Plông district), Kon Tum province (Vietnam)

Total items: 4
Total pages: 1
Organisms

- Specimen ID
- 0000001190082
- Species
- Phialemonium dimorphosporum
- Strain
- MSU_FS-03488
- Place of isolation
- Район Манг Занг (Mang Yang districts), Gia Lai province (Vietnam)
- Placename
- Адзун (A Yun commune)

- Specimen ID
- 0000000905854
- Species
- Phialemonium dimorphosporum
- Strain
- MSU_FS-02710
- Place of isolation
- Район Кон Плонг (Kon Plông district), Kon Tum province (Vietnam)
- Placename
- Манг Кань (Măng Cành commune)
- Specimen ID
- 0000000905852
- Species
- Phialemonium dimorphosporum
- Strain
- MSU_FS-02709
- Place of isolation
- Район Кон Плонг (Kon Plông district), Kon Tum province (Vietnam)
- Placename
- Манг Кань (Măng Cành commune)

- Specimen ID
- 0000000904270
- Species
- Phialemonium dimorphosporum
- Strain
- MSU_FS-01410
- Place of isolation
- Район Лак (Lắk district), Đắk Lắk province (Vietnam)
- Placename
- Бонг Кранг (Bông Krang)